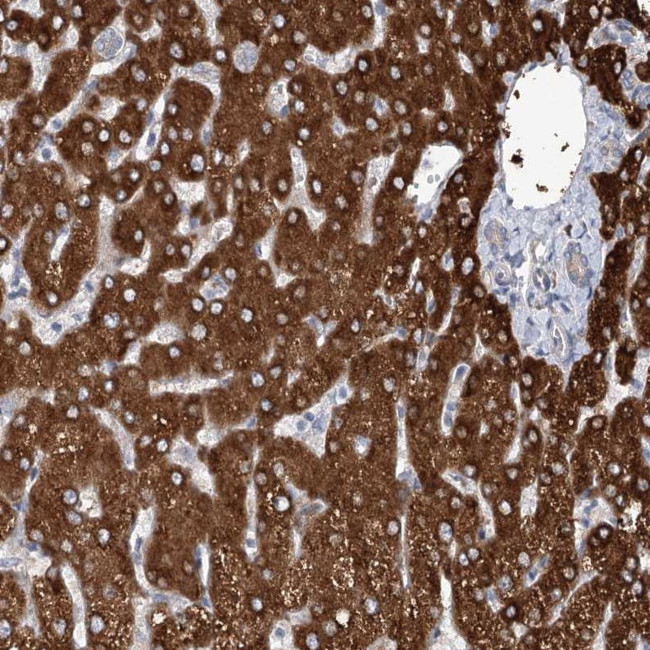
CIB4 Antibody in Immunohistochemistry (Paraffin) (IHC (P))

Search
Invitrogen
CIB4 Polyclonal Antibody
{{$productOrderCtrl.translations['antibody.pdp.commerceCard.promotion.promotions']}}
{{$productOrderCtrl.translations['antibody.pdp.commerceCard.promotion.viewpromo']}}
{{$productOrderCtrl.translations['antibody.pdp.commerceCard.promotion.promocode']}}: {{promo.promoCode}} {{promo.promoTitle}} {{promo.promoDescription}}. {{$productOrderCtrl.translations['antibody.pdp.commerceCard.promotion.learnmore']}}
产品信息
PA5-57532
种属反应
宿主/亚型
分类
类型
抗原
偶联物
形式
浓度
规格
纯化类型
保存液
内含物
保存条件
运输条件
RRID
产品详细信息
Immunogen sequence: ACPSLKIEYA FRIYDFNENG FIDEEDLQRI ILRLLNSDDM SEDLLMDLTN HVLSESDLDN DNMLSFSEFE HAMAKSPDFM NSFRIHFWGC
Highest antigen sequence identity to the following orthologs: Mouse - 90%, Rat - 92%.
靶标信息
CIB4 (calcium and integrin-binding family member 4) is a 185 amino acid protein that contains three EF-hand domains. CIB4 is closely related to CIB (CIB has one less EF-hand domain), which is known to bind to Integrin alpha II beta in platelets and is involved in signal transduction. The gene encoding CIB4 maps to human chromosome 2, which houses over 1,400 genes and comprises nearly 8% of the human genome. Harlequin icthyosis, a rare and morbid skin deformity, is associated with mutations in the ABCA12 gene, while the lipid metabolic disorders itosterolemia is associated with defects in the ABCG5 and ABCG8 genes. Additionally, an extremely rare recessive genetic disorder, Alstrom syndrome, is caused by mutationsin the ALMS1 gene, which maps to chromosome 2.
仅用于科研。不用于诊断过程。未经明确授权不得转售。
篇参考文献 (0)
生物信息学
蛋白别名: Calcium and integrin-binding family member 4
基因别名: CIB4; KIP4
UniProt ID: (Human) A0PJX0
Entrez Gene ID: (Human) 130106